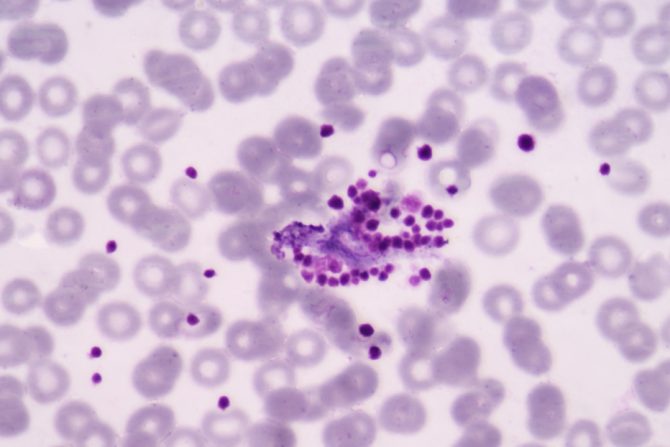
Pseudotrombocitopenija

Pseudotrombocitopenija dovodi do pogrešne dijagnoze, pa i lečenja
Klinička slika, u nekim slučajevima, može da se razlikuje od realnog zdravstvenog stanja pacijenta, kada najveći rizik predstavljaju apsolutno beskorisne terapije, koje mogu čak i da ugroze život čoveka
Pseudotrombocitopenija je neuobičajen i često neprepoznat fenomen koji dovodi do grešaka u tumačenju broja trombocita koji za posledicu imaju i beskorisno i neodgovarajuće lečenje. Relativno je čest nalaz u kliničkim laboratorijama, koji može da dovede do dijagnostičkih grešaka, nepotrebnog lečenja i opasnih terapijskih intervencija. S obzirom na to da je trombocitopenija česta kod kritično bolesnih pacijenata, a označava nizak nivo trombocita, kliničke posledice sa potencijalnim aktivnostima opasnim po život, kao što je nepotrebna transfuzija trombocita, neodgovarajući tretman, poput splenektomije (uklanjanje slezine) ili kortikosteroida, i dalje se sreću kada se PTCP ne otkrije na vreme. Fenomen je još složeniji kada se javlja sa različitim antikoagulansima i obično se može identifikovati pregledom razmaza periferne krvi.
Pseudotrombocitopenija javlja se kod pacijenata koji imaju različite poremećaje
Prijavljena po prvi put 1969. godine, pseudotrombocitopenija (PTCP) sve češće se opisuje kod pacijenata koji pate od različitih poremećaja, a u novije vreme čak i kod pacijenata koji su dobili covid 19 infekciju. Pseudotrombocitopenija ne predstavlja hemoragični ili trombotički rizik za pacijenta.
Osoba koja ima pseudotrombocitopeniju ne zahteva kliničko ili laboratorijsko pracćenje za ovo benigno stanje. Jedini klinički problem leži u teškom prepoznavanju PTCP, što bi potencijalno moglo da izazove neodgovarajuću transfuziju trombocita, nepotrebno dodatno testiranje i kašnjenje u dijagnostičkim ili terapijskim procedurama.
Pseudotrombocitopenija je registrovana kod pacijenata pogođenih širokim spektrom poremećaja, uključujući autoimune bolesti, hronične inflamatorne bolesti, virusne i bakterijske infekcije, metaboličke sindrome i neoplastične bolesti, kao i nakon alogene transplantacije matičnih ćelija i kod zdravih subjekata.
Ove veoma različite kliničke situacije potvrđuju da pseudotrombocitopenija nije uzrokovana ili povezana sa određenom bolešću ili upotrebom određenih lekova, iako su opisani povremeni slučajevi u kojima se pseudotrombocitopenija pojavila nakon primene valproične kiseline (valproata), olanzapina, insulina ili levofloxacina.
Rizik od nepotrebnih terapija, pa čak i uklanjanja organa
Medicinski izveštaji opisuju pacijente sa pseudotrombocitopenijom koji su bili hospitalizovani i podvrgnuti nepotrebnim transfuzijama koncentrata trombocita, drugi su bili podvrgnuti punkciji koštane srži i biopsiji kostiju, a neki su i dalje primali dugotrajnu terapiju kortizonom, intravenozne imunoglobuline, ili im je čak uklonjena slezina. Ukoliko se pseudotrombocitopenija kasno prepozna tmože da izazove neopravdanu uzbunu kod pacijenta, kao i mere predostrožnosti zbog straha od krvarenja usled trombocitopenije.
Kod nekih zdravih ljudi, pseudotrombocitopenija može da traje duže od 20 godina. Dakle, nalaz autoantitela pseudotrombocitopenije, kod naizgled zdravog čoveka, ne ukazuje na veći rizik za budući razvoj određene bolesti. Međutim, kod najmanje polovine pacijenata utvrđeno je da pseudotrombocitopenija nije bila prisutna prethodnih godina već se pojavila iznenada, bez očiglednog uzroka.
Nakon što se pojavi, pseudotrombocitopenija obično ostaje neograničeno u organizmu, ali u nekim slučajevima je prolazna i nestaje nakon nekog vremena. Potencijalni problem nastaje kada ljudi sa pseudotrombocitopenijom zahtevaju hiruršku intervenciju pod hipotermijom, kao što se dešava kod operacije srca.
Nije utvrđeno da je pseudotrombocitopenija nasledna
Pseudotrombocitopenija često se naziva medicinskim fenomenom i upravo zbog toga se izučava sa mnogo aspekata. Jedan od njih je, dosta zanimljiv je onaj koji se odnosi na moguće implikacije transfuzije krvi dobijene od davaoca sa pseudotrombocitopenijom. Prema iskustvu kliničara, nisu se pojavili problemi kod primalaca, čak ni pojava pseudotrombocitopenije, što ukazuje da se krv zdravih ljudi sa pseudotrombocitopenijom može koristiti u transfuzijskoj terapiji.
Važno je napomenuti da u retkim slučajevima pseudotrombocitopenija može da bude povezana sa hroničnom autoimunom trombocitopenijom u kom slučaju pseudotrombocitopenija artefaktički dodatno snižava broj trombocita. Nije utvrđeno da je pseudotrombocitopenija nasledna, osim što je zabeležen slučaj prolazne kongenitalne pseudotrombocitopenije usled transplacentalnog prenosa IgG antitela sa majke na dete.
eKlinika zadržava sva prava nad sadržajem. Za preuzimanje sadržaja pogledajte uputstva na stranici Uslovi korišćenja.


